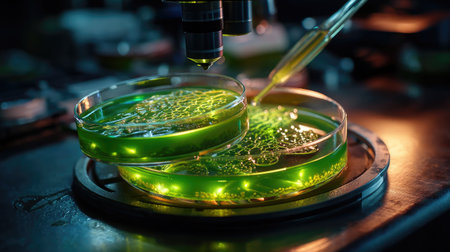
This captivating image captures a laboratory setup featuring petri dishes filled with green algae, illuminated under a microscope, showcasing scientific research.の素材

素材 - This captivating image captures a laboratory setup featuring petri dishes filled with green algae, illuminated under a microscope, showcasing scientific research.
作品情報
This captivating image captures a laboratory setup featuring petri dishes filled with green algae, illuminated under a microscope, showcasing scientific research.
- ID:254861238
- 作品種別:
- 作者名:PRAPATSARA THIPYASAN
キーワード
- algae
- analysis
- analysis tools
- aquatic
- aquatic life
- biology
- culture
- discovery
- ecosystem
- education
- environment
- equipment
- examination
- experimentation
- field
- flora
- green
- growth
- innovation
- investigation
- laboratory
- laboratory work
- light
- microbe
- microbiology
- microscope
- nature
- observation
- organic
- organic matter
- petri dish
- pipette
- precision
- process
- research
- research tools
- sample
- science
- scientific inquiry
- scientific method
- setup
- specimen
- specimen handling
- study
- technology
- visualization
類似作品
person standing...
Person meditate...
Beautiful cinem...
Young woman sit...
Woman wearing f...
Set of photo fr...
Man standing at...
young woman sta...
astronaut, surr...
A captivating s...
Handsome young ...
Landscape of co...
View of a vibra...
Vibrant trees s...
Beautiful autum...
Crowds fill a l...
Waterfall in th...
Misty valley la...
A person captur...
Road in the mou...
3d illustration...
astronaut, surr...
A beautiful wat...
Isolated lookou...
Beautiful cinem...
A girl gazes ou...
Panoramic view ...
Serene Waters A...
lake and mounta...
Camera lens wit...
Imposing storm ...
A breathtaking ...
Smartphone fram...
Vibrant hues of...
Abstract backgr...
Boat on the lak...
A mountain at s...
Mountain lake a...
Experience the ...
A captivating u...
Individual clim...
Silhouetted mou...
A solitary figu...
Railway station...
A breathtaking ...
A serene landsc...
Foggy morning o...
A body of water...
A breathtaking ...